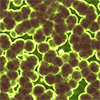

May 30, 2022 (Nanowerk News) Triboelectric nanogenerators (TENGs) can collect mechanical energy extensively through contact initiation and electrostatic induction. TENGs have shown a wide range of applications in self-powered sensors and mechanical energy harvesting. The contact-separation mode is one of the most fundamental and common modes of working. Previous studies...
Ultrasound-guided microbubbles boost immunotherapy efficacy
May 30, 2022 (Nanowerk News) Researchers at The University of Texas MD Anderson Cancer Center have developed an ultrasound-guided cancer immunotherapy platform that generates systemic antitumor immunity and improves the therapeutic efficacy of immune checkpoint blockade. The findings from the preclinical study were published today in Nature Nanotechnology ("Cancer immunotherapy...
Engineers boost signals from fluorescent nanosensors
May 30, 2022 (Nanowerk News) Fluorescent sensors, which can be used to label and image a wide variety of molecules, offer a unique glimpse inside living cells. However, they typically can only be used in cells grown in a lab dish or in tissues close to the surface of the...
Turning high-rise buildings into batteries
May 30, 2022 (Nanowerk News) The world’s capacity to generate electricity from solar panels, wind turbines, and other renewable technologies has been steadily increasing over the last few years, and global renewable electricity capacity is expected to rise still further by more than 60% from 2020 levels by 2026. This...
Physicists take the world’s first image of a 3D magnetic field
May 30, 2022 (Nanowerk News) A Dresden research team led by solid-state physicist Dr. Axel Lubk has succeeded in imaging the magnetic field of tiny magnetic nanovortices - called skyrmions - in three dimensions with a resolution of less than 10 nm. This is the first time ever that this...
Multi-functional bandage helps wounds to heal
May 30, 2022 (Nanowerk News) Researchers at the Technical University of Munich (TUM) have developed a film that not only protects wounds similar to the way a bandage does, but also helps wounds to heal faster, repels bacteria, dampens inflammation, releases active pharmaceutical ingredients in a targeted manner and ultimately...
A step closer to next-generation semiconductors
May 30, 2022 (Nanowerk News) To realize artificial intelligence systems and autonomous driving systems, which is often seen in movies, in everyday life, processors that function as the brain of computers must be able to process more data. However, silicon-based logic devices, which are essential components of computer processors, have...
Nanotechnology Now – Press Release: A sunlight-driven self-healing anti-corrosion coating
Home > Press > A sunlight-driven self-healing anti-corrosion coating CORROSION PROTECTION MECHANISM OF THE INTACT, DAMAGED AND HEALED SHCS CREDIT ZHIFENG LIN, WEIHUA LI Abstract:Metal materials directly exposed to air, water or other corrosive media are prone to damaged due to various physical and chemical changes, causing huge resource waste...
Nanotechnology Now – Press Release: New route to build materials out of tiny particles
Home > Press > New route to build materials out of tiny particles Four cubic colloids made from glass CREDIT TU Delft Abstract:Researcher Laura Rossi and her group at TU Delft have found a new way to build synthetic materials out of tiny glass particles so-called colloids. Together with...
Nanotechnology Now – Press Release: Nanoscale chemically ordered-disordered domains in Fe3Pt alloys and their three-dimensional interface and lattice strain
Home > Press > Nanoscale chemically ordered-disordered domains in Fe3Pt alloys and their three-dimensional interface and lattice strain The three-dimensional distribution of the Fe3Pt alloys prepared in this study with different degrees of chemical ordering is plotted in the figure (top). The size of ordered/disordered nanodomains and the lattice strain...